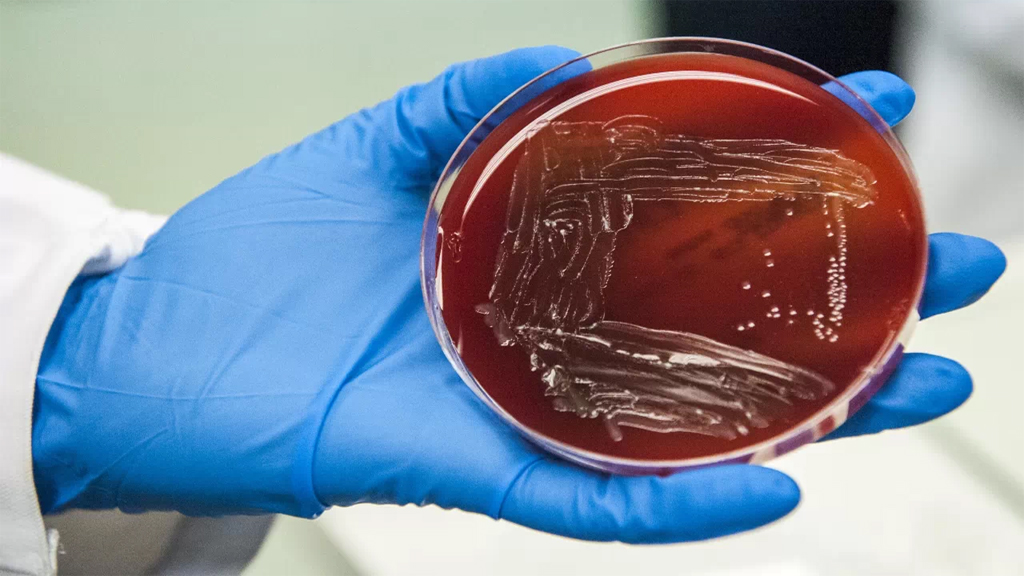

Denuncian el aborto de dos mellizos en mayo por listeriosis
La denuncia parte de la asociación del 'Defensor del Paciente'.
Una mujer de Madrid abortó en mayo a los mellizos que gestaba.
Había consumido carne mechada "La Mechá" en Sevilla durante los días de Semana Santa.
La asociación del 'Defensor del Paciente' ha presentado una denuncia en un juzgado de Sevilla por el aborto de una mujer embarazada de mellizos a consecuencia de la listeriosis. Ocurrió en mayo en Madrid. La mujer y su marido habían consumido carne mechada "La Mechá" en Sevilla durante los días de Semana Santa
La familia quiere que se determine la responsabilidad de Magrudis y también ha denunciado al Ayuntamiento de Sevilla y a la Junta por no abrir una investigación e informar a la familia. La Asociación el Defensor del Paciente recuerda que ya son varios los casos de infección por Listeria relacionados con Magrudis ocurridos meses antes de la alerta sanitaria de agosto.
En este caso, la mujer y su marido, ambos de origen sevillano, estuvieron en Semana Santa en Sevilla y consumieron carne mechada de la empresa Magrudis. De vuelta a la capital, estando embarazada de 21 semanas de mellizos, acudió a urgencias de un hospital madrileño, allí le detectaron una infección Grave









